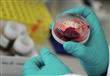
تحديد نسبة الفيروسات الكبدية دون تدخل بشري المنوفي

للمرة الأولى بمصر.. تحديد نسبة الفيروسات الكبدية دون تدخل بشري المنوفية
كتب : مصراوي
تحديد نسبة الفيروسات الكبدية دون تدخل بشري المنوفي
المنوفية - هبة سالم:
أعلن الدكتور أحمد شعراوى عميد معهد الكبد القومي بمحافظة المنوفية ، اليوم السبت، عن إقتناء المركز لجهاز " fast pcr" لأول مره فى مصر للحصول على أدق وأسرع نتيجة لتحديد نسبة الفيروسات الكبدية فى الدم دون تدخل بشري, والحصول على النتيجة خلال ساعة من سحب العينة وبدقة عالية.
وأكد شعراوى، أن هذا النوع من التحاليل يستخدم فيه تكنولوجيا متقدمة لا تترك أى مجال للخطأ ويستغرق ما يقرب من 20 دقيقة فقط للانتهاء منها وإظهار نتيجتها.